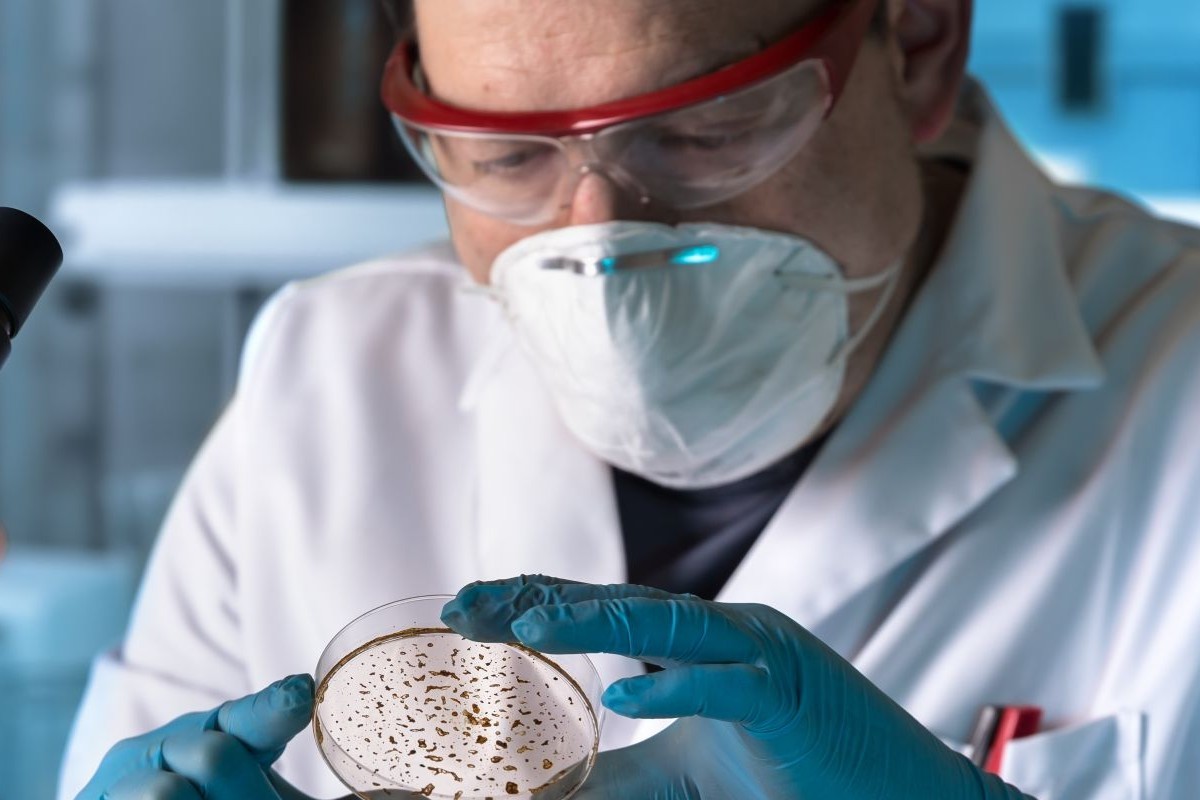

Na bakteriální infekce, kterých se dnes příliš nebojíme, lidé ještě před sto lety běžně umírali. Zvrátit to pomohl objev antibiotik. Vděčíme za něj práci velkého množství lidí a zároveň několika bizarním šťastným náhodám. Co stálo za vznikem penicilínu?
Illinoiský prodejce ovoce a zeleniny se trochu potí – vyndal z vystavené bedny plesnivý grapefruit, ale všimla si toho zákaznice a začala se zvědavě vyptávat. Zelinář by to nejradši nechal být – ještě aby si lidé začali myslet, že jeho zboží není čerstvé! Zákaznici, Mary Huntovou (1910–1991), ale zajímá, jestli prodavač nemá ještě další plesnivé ovoce. Když jí pár kusů ukáže, bedlivě si je prohlíží a poprosí ho, aby pro ni takové schovával. Prodavač ví, že je pracuje v laboratoři na nějakém projektu souvisejícím s válkou, a tak se radši neptá. O pár let později mu přijde Hunotvá říct, že trochu plesnivá texaská dýně, kterou jí před…